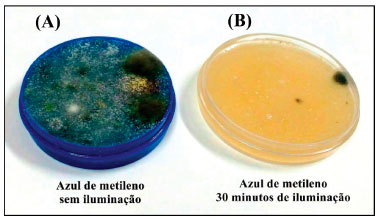

Educação
|
|
| Atividade fotodinâmica e conceitos: um experimento demonstrativo Photodynamic activity and concepts: a demonstrative experiment |
|
Ana Claudia Pedrozo da SilvaI; Camila Fabiano de FreitasI; André Luiz TessaroII; Wilker CaetanoI; Silvana Maria de Oliveira SantinI,*; Noboru HiokaI; Graciana Freitas PaliotoII
I. Departamento de Química, Universidade Estadual de Maringá, 87020-900 Maringá - PR, Brasil Recebido em 14/11/2017 *e-mail: smoliveira@uem.br A simple and low cost experiment is proposed to chemistry students associating the Photodynamic Activity involving Chemical and Biochemical concepts. The inclusion of this experiment in undergraduate courses in Chemistry promotes interdisciplinarity and contextualization, combining current and relevant topics to the teaching of program content. The experiment used the Methylene Blue and Erythrosine B as dyes to demonstrate the photodynamic action of these photosensitizers in the inhibition of microbial growth. Both dyes presented satisfactory results against environmental microorganisms. The growth inhibition was caused exclusively by the photochemical processes undergone by the dye/light/oxygen, with LED light exposure. INTRODUÇAO Ao longo dos séculos a luz vem sendo empregada na medicina, tendo registros datados há mais de 4000 anos no Egito, na Grécia e na India, nos quais a luz solar era empregada na cura de vários distúrbios. Pensava-se que somente a luz solar era responsável pela cura de doenças como vitiligo, psoríase, raquitismo e até psicose. Com o avanço científico notou-se que geralmente o efeito era obtido após a ingestao de plantas, seguida pela exposiçao solar.1 Ressalta-se que naquele momento, nao se conhecia a existência de raios ultravioleta (UV), que foram descobertos após 1801.2 Anos mais tarde pesquisadores perceberam que o efeito terapêutico estava relacionado à combinaçao da luz solar com os pigmentos presentes nas plantas ingeridas, ou seja, aos corantes. A idéia de usar um corante como agente terapêutico surgiu de uma observaçao realizada por Oscar Raab, na época aluno do professor von Tappeiner no Instituto Farmacológico do Ludwig Maximilian, na Universidade de Munique (1897-1898). Raab realizava um estudo sobre a letalidade do vermelho de acridina sobre o protozoário causador da malária (Paramecium caudatum). Ele identificou letalidade reduzida em um dia chuvoso, entretanto, em um dia ensolarado, o efeito foi pronunciado. A partir desta observaçao, ele concluiu que a luz ativava o corante, induzindo o microrganismo à morte. Em 1903, é reportada a primeira utilizaçao fotodinâmica de corantes no tratamento de tumores por von Tappeiner e Jesionek, utilizando o corante eosina.3 A partir de entao, inúmeros estudos foram realizados com intuito de compreender os efeitos fotodinâmicos acarretados pela combinaçao da luz com os corantes. Descobriu-se que a atividade só era efetiva se a luz empregada tivesse emissao em comprimentos de onda condizente com o espectro de absorçao dos corantes, processo fotoquímico primário, e se houvesse a presença de oxigênio molecular (3O2). Assim surgiu a base da chamada Terapia Fotodinâmica (TFD), envolvendo a ativaçao de um composto fotossensibilizador (FS, corante) por luz de comprimento de onda adequado na presença de oxigênio. Dessa interaçao resulta a geraçao de oxigênio singleto (1O2) e espécies reativas de oxigênio (EROs), que sao responsáveis pela morte de células in situ.3,4 Após a irradiaçao do fotossensibilizador no tecido biológico alvo, o mesmo é promovido a um estado singleto excitado (1FS*), podendo entao sofrer mudança em sua multiplicidade de spin através do cruzamento inter-sistemas, levando-o ao estado tripleto excitado (3FS*). O estado tripleto possui maior tempo de vida, o que faz com que reaçoes fotoquímicas importantes geralmente ocorram nesse estado. Tendo o cromóforo chegado à 3FS*, dois mecanismos sao propostos para o processo que leva à geraçao de espécies citotóxicas. No mecanismo Tipo I, ocorre a transferência de elétrons entre o 3FS* e substratos biológicos, gerando íons-radicais que tendem a reagir com o oxigênio formando as chamadas espécies reativas de oxigênio, como o ânion superóxido (O2-) e o radical hidroxila (OH•). Já no mecanismo Tipo II, ocorre a transferência de energia do 3FS* diretamente para o oxigênio em seu estado fundamental, que já é tripleto (3O2), levando à formaçao de oxigênio singleto (1O2), espécie altamente oxidante. Ambos os caminhos podem levar à morte celular, no entanto, o mecanismo Tipo II é proposto como principal via de açao da TFD.5 A partir da década de 50, com os estudos de Schwartz e Lipson para tratamento do câncer de mama, o desenvolvimento dos primeiros medicamentos foi iniciado.1 Na década de 70, os trabalhos de Dougherty sobre derivados hematoporfirínicos culminaram no desenvolvimento do princípio ativo Photofrin®, o primeiro FS com uso aprovado pelos órgaos reguladores, fato ocorrido somente no ano de 1998.5-7 A continuidade dos estudos levou ao desenvolvimento dos medicamentos da chamada segunda geraçao, com dois novos fármacos aprovados pela agência americana FDA (Food and Drug Administration) em 1999: o Levulan®Kerastick, uma pró-droga para lesoes de pele, e o Visudyne® para degeneraçao macular da retina, cujo princípio fotoativo é uma benzoporfirina. A potencialidade da técnica na Inativaçao Fotodinâmica de Microrganismos (IFDMO) ou Terapia Fotodinâmica Antimicrobiana (TFDA), em bactérias, fungos e vírus já é conhecida há muitos anos.8-10 No entanto, o desenvolvimento de drogas antimicrobianas, como a penicilina (durante a II Guerra Mundial), praticamente inutilizou fotossensibilizadores como ativos antimicrobianos.9,11 O atual destaque da IFDMO (ou TFDA) se deve principalmente à disseminaçao da AIDS e do aumento de casos de infecçoes hospitalares e bactérias resistentes a antibióticos.12 A técnica oferece vantagens como um amplo espectro de açao, sendo eficiente inclusive sobre microrganismos resistentes a antibióticos e apresentando menores efeitos colaterais nocivos quando comparada a outros tratamentos.8,12,13 Além disso, uma vez que a inativaçao se dá por meio da produçao de espécies altamente reativas com ataque a múltiplos alvos celulares, nao se considera possível o desenvolvimento de resistência microbiana. Por essas vantagens, a utilizaçao da TFDA tem se mostrado relevante, por exemplo, na esterilizaçao de bolsas de sangue, na periodontia e no tratamento e conservaçao de alimentos.12 Hoje, os tratamentos fotodinâmicos sao utilizados nos EUA, Canadá, Japao, Europa entre outros. No Brasil, ainda que tímido, emprega-se o tratamento em centros oncológicos como o Hospital Amaral Carvalho de Jaú,14 diversos centros oftalmológicos no tratamento da degeneraçao macular da retina, em centros odontológicos para eliminaçao de bactérias relacionadas à infecçoes endodônticas e periodontais,15 no tratamento contra cáries16 e em implantes dentários.17 A TFDA também já é utilizada em tratamentos dermatológicos para doenças de pele como as ceratoses actínicas e carcinomas basocelulares18 e no tratamento de úlceras em pacientes diabéticos.19,20 Quanto a escolha dos corantes FS para utilizaçao em TFD, deve ser baseada em suas características físico-químicas, como alta absorçao de luz e geraçao de 1O2. Além disso, é imprescindível que o FS apresente farmacocinética favorável, baixa toxicidade no escuro, elevada estabilidade, fácil obtençao e preferencialmente baixo custo.21 A solubilidade do FS em meio biológico é outro fator crucial, já que os processos de autoagregaçao do FS diminuem consideravelmente a geraçao de 1O2 devido à processos de auto-colisoes.5,7 Dentre os fotossensibilizadores que detém essas características, pode-se destacar o corante catiônico Azul de Metileno (AM, Figura 1A). O AM é um corante da classe dos fenotiazínicos muito utilizado na área microbiológica e comercializado como antisséptico. Sem a presença de luz também vem sendo utilizado na área médica no tratamento da metahemoglobinemia e tem despertado interesse como potencial princípio ativo no tratamento da doença de Alzheimer.22,23
 Figura 1. Estruturas dos fotossensibilizadores (A) Azul de Metileno e (B) Eritrosina B
Para a TFD, o Azul de Metileno é um interessante fotossensibilizador devido sua alta absorçao de luz na regiao do vermelho (ε664 = 39,0x103 L mol-1 cm-1)24 e um bom rendimento quântico de oxigênio singleto (ΦΔ1O2 = 0,50) em água.25 Em termos de aplicaçao fotodinâmica, o AM tem sido extensivamente reportado na literatura em tratamentos de casos de melanomas,26 células tumorais cerebrais27 e células de rim.28 Para a TFDA, o AM também se mostrou eficaz contra bactérias resistentes29,30 e no tratamento de doenças negligenciadas como a Leishmaniose cutânea31 e casos de osteomielite em pacientes diabéticos.32 Outro FS altamente promissor é o corante xantênico Eritrosina B (ERI), cuja estrutura é representada na Figura 1B. Em condiçoes de pH fisiológico (~ 7,4), a ERI encontra-se na forma dianiônica apresentando elevado rendimento quântico de oxigênio singleto (ΦΔ1O2 = 0,63) e alta absortividade molar na regiao do verde (ε532 = 96,6x103 L mol-1 cm-1) em água.33,34 Este composto possui a vantagem de ser aprovado para o uso na ausência de luz em alimentos e em tratamentos odontológicos como evidenciador da placa bacteriana. A ERI/Luz tem sido testada com sucesso em tratamentos do biofilme dental via TFDA contra o microrganismos Streptococus mutans.35,36 Estudos recentes também demonstraram efeitos significativos da ERI associada à luz na inibiçao de patógenos alimentares.37 Outro aspecto crucial em tratamentos fotodinâmicos é a escolha correta da fonte de luz. Essa seleçao deve ser feita com base na regiao de absorçao do FS e no tipo de lesao a ser tratada. A fonte mais utilizada ainda é o LASER, devido sua elevada potência, e sua luz pode ser dirigida ao local da lesao por meio de fibras óticas. No entanto, o LASER é extremamente custoso e a pequena dimensao de seu foco de luz é restritiva a lesoes menores. Este vem sendo substituído por alternativas muito mais econômicas, como os diodos emissores de luz (LED, do inglês, Light Emitting Diode),3 sendo que um conjunto de unidades LED permite irradiar lesoes de áreas grandes. Enfatiza-se que a fotoexcitaçao exige a sobreposiçao entre o espectro de absorçao do FS e o espectro de emissao da fonte de luz (processo fotoquímico primário). Assim, quanto maior a sobreposiçao espectral e a irradiância (potência por área) da luz, maior será o número de fótons absorvidos pelo FS e maior a geraçao de espécies citotóxicas, acentuando a morte celular.38 Toxicidade mínima em tecidos normais, efeitos sistêmicos negligenciáveis, morbidade reduzida ao longo prazo e o nao aparecimento de resistência tumoral e microbiana fazem da TFD/TFDA uma opçao terapêutica valiosa. Além de todos esses benefícios, o procedimento ainda envolve uma quantidade significativa de conceitos físico-químicos, fotofísicos e biológicos que podem e devem ser abordados no ensino. A necessidade por práticas de ensino que envolvam conceitos multidisciplinares é latente e o número de publicaçoes nesse contexto tem crescido significativamente.39-41 Contudo, no que concerne à técnica fotodinâmica, seu uso para esse fim é escasso. Em cursos de Química a TFD é descrita em exemplos de reaçoes fotoquímicas em tópicos de Cinética Química e Espectroscopia, como no livro de Físico-Química dos autores Peter Atkins e Julio de Paula.42 No campo de pesquisas, vários grupos nas pós-graduaçoes em Química, Física, Odontologia, Farmácia, Bioquímica, Zootecnia, Agronomia, Veterinária, Medicina, Fisiologia, entre outros, inclusive no Brasil, têm investigado os mais diferentes fotossensibilizadores, com diversas modificaçoes em suas formulaçoes e técnicas de aplicaçao, voltados a diferentes patologias. No sentido de abordar o elevado potencial da TFD/TFDA em tratamentos oncológicos e microbiológicos, e também visando o estreitamento entre o ensino de graduaçao com pesquisas científicas de ponta, esse trabalho demonstra a possibilidade de contextualizaçao da terapia por meio de um experimento simples e de baixo custo. O experimento pode ser aplicado em cursos de nível Superior de Química e áreas correlatas, relacionando a aplicaçao de reaçoes fotoquímicas na TFDA para esterilizaçao de materiais e tratamentos biomédicos. Para a realizaçao dos experimentos, amostras de microrganismos foram obtidas do ambiente. Escolheram-se dois fotossensibilizadores para análise quantitativa do experimento, o Azul de Metileno e a Eritrosina B, ambos de fácil obtençao e baixo custo, iluminados com dispositivos de LED vermelho e verde, respectivamente. Para uma abordagem efetiva, sugere-se a leitura preliminar dos artigos: "Terapia Fotodinâmica: princípios, potencial de aplicaçao e perspectivas" do autor Antônio Eduardo da Hora Machado;3 "Terapia Fotodinâmica: aspectos farmacológicos, aplicaçoes e avanços recentes no desenvolvimento de medicamentos" dos autores Símplicio, Maionchi e Hioka;4 e "Inativaçao Fotodinânica de microrganismos" de Janice Perussi,12 nestes casos, todos artigos publicados na revista Química Nova visando o Ensino de Química no Brasil.
PARTE EXPERIMENTAL Materiais O Azul de Metileno é facilmente adquirido em casas farmacêuticas na forma de soluçao aquosa 1% (empresa ADV). A Eritrosina B é igualmente de fácil aquisiçao na forma de corante alimentício líquido da marca Mix de cor "rosa cereja", adquirido em mercados assim como o caldo de carne. Agar-ágar foi adquirido da Ingá Alimentos - Produtos Naturais na forma de pó levemente amarelado vendido em embalagens de 50 g, e as placas de Petri plásticas foram compradas em lojas de embalagens. Foram utilizados LEDs com máximo de emissao em 506 nm (verde, para a ERI) e 632 nm (vermelho, para o AM), facilmente encontrados em casas de produtos eletrônicos. Cada fonte de iluminaçao apresentava um conjunto de seis LEDs, cuja confecçao segue descrita no Material Suplementar (Figura 1S). O meio de cultura foi preparado em uma chapa de aquecimento (marca Kasvi). Os espectros de absorçao e de fluorescência dos FS foram obtidos respectivamente em um espectrofotômetro Varian Cary-60 e um espectrofluorímetro Varian Cary-Eclipse. A irradiância absoluta dos LEDs foi avaliada num espectroradiômetro obtido pela Ocean Optics modelo USB2000+. Estes últimos equipamentos na realidade sao opcionais, porém seu uso é desejável, pois auxiliam bastante o entendimento dos conceitos discutidos quantitativamente no trabalho. Caso deseje, o professor pode optar pela utilizaçao de meios de cultura nao seletivos e próprios para o crescimento microbiano, como o Brain Heart Infusion (BHI) ou o Plate Count Agar (PCA), evitando assim impurezas procedentes do caldo de carne. Também é possível realizar os procedimentos utilizando corantes de grau analítico, para evitar a presença de excipientes e contaminantes. Métodos Preparo das soluçoes de corantes As soluçoes dos corantes foram preparadas separadamente por meio da adiçao de uma gota de cada um dos compostos comerciais em 200 mL de água destilada. Dessa forma, ambos os FS chegaram à concentraçoes próximas a 6,0x10-6 mol L-1. A concentraçao de cada FS foi determinada por meio do espectro de absorçao de cada soluçao utilizando os valores de absortividade molar do AM ε664nm = 39,0x103 L mol−1 cm−1 e da ERI ε532nm = 96,6x103 L mol−1 cm−1 em água e soluçao tamponada (pH 7.4), respectivamente.24,34 Foram considerados os valores de absortividade molar das substâncias puras, uma vez que a proporçao de outros compostos é consideravelmente menor nao alterando assim o perfil espectrofotométrico dos corantes. Preparo do meio de cultura e distribuiçao em placas Para o preparo do meio de cultura sólido, foram adicionados 1,6 g de agar-agar e ¼ de um cubo de caldo de carne (2,4 g) a 100 mL de água destilada. A mistura foi levada ao aquecimento e permaneceu em ebuliçao por cinco minutos. Após esse procedimento, 3 mL do meio de cultura foram transferidos para a placa e aguardou-se o processo de gelificaçao. Para evitar a contaminaçao do meio de cultura pelo ar na transferência para a placa de controle negativo, utilizou-se um fogareiro para que todo o processo fosse feito próximo à zona estéril da chama. O meio de cultura para o controle positivo foi preparado como mencionado acima e a transferência para as placas ocorreu na ausência da chama. Nesse caso, após a solidificaçao do ágar, as placas foram contaminadas passando-se levemente o dedo indicador por toda a superfície do meio de cultura. Antes deste procedimento o responsável pela contaminaçao tocou/manuseou diversas maçanetas de portas do ambiente. O controle positivo 1 nao recebeu nenhum tipo de tratamento. Já os controles 2 (sem AM) e 3 (sem ERI) foram iluminados a uma distância de 5 cm por 30 minutos com LEDs vermelhos (LEDverm) e verdes (LEDverd), respectivamente. A iluminaçao foi iniciada imediatamente após a contaminaçao das placas (Figura 2S). Para os ensaios na presença dos fotossensibilizadores o meio de cultura e a contaminaçao foram feitos como descritos anteriormente. Nesses casos, antes da solidificaçao 2 mL da soluçao de corante foram adicionados. As amostras foram submetidas a 30 minutos de iluminaçao (ou nao - controle escuro) com LED vermelho (AM, LEDverm) ou verde (ERI, LEDverd), nas mesmas condiçoes já descritas. Ao todo foram preparadas oito amostras, cujos detalhamentos encontram-se resumidos na Tabela 1.
Análise qualitativa dos resultados Acompanhou-se o tempo de crescimento dos microrganismos, sendo que esse é diretamente influenciado pela temperatura e, portanto, por questoes climáticas. Como o experimento descrito neste trabalho foi realizado durante o período de inverno, todas as imagens foram coletadas após dez dias da contaminaçao/tratamento das placas. Medida da irradiância dos LEDs e cálculo do número de fótons absorvidos Os cálculos de potência absorvida (PAbs) e número de fótons absorvidos (NAbs) foram realizados tomando-se a potência da luz incidente (PEm) e o espectro de absorçao do FS seguindo a metodologia proposta por Rabello e colaboradores.38 Uma descriçao detalhada dessa metodologia segue descrita no Material Suplementar. Os cálculos sugeridos, apesar de auxiliarem uma maior compreensao quantitativa do experimento, nao sao totalmente necessários, cabendo ao professor esta decisao.
RESULTADOS E DISCUSSAO O controle microbiano consiste em uma série de procedimentos que impedem a proliferaçao de microrganismos existentes em determinados utensílios ou ambientes. Nesse sentido, o controle negativo é uma amostra importante em análises microbiológicas para demonstrar que o crescimento microbiano ocorre exclusivamente devido à contaminaçao intencional do meio de cultura. Para evitar que o meio de cultura seja contaminado pelo contato com o ar na transferência do béquer para a placa, esse processo foi realizado próximo a uma chama. Este método de transferência próximo à zona estéril da chama e a ausência de qualquer outro tipo intencional de contaminaçao resultou em uma placa sem qualquer crescimento microbiano visível, como pode ser observado na Figura 2A.43
 Figura 2. Placas de (A) controle negativo e (B) controle positivo 1 (sem iluminaçao)
Já o controle positivo (Figura 2B), mostra como ocorre a contaminaçao, sem que seja realizado qualquer tratamento no intuito de controlar o crescimento microbiano. Como citado anteriormente na seçao experimental, antes de contaminar as placas, o responsável por esta etapa abriu/fechou diversas portas, representando assim a contaminaçao de maçanetas de uso comum. A literatura já tem reportado a presença da bactéria Gram-positiva Staphylococcus aureus em maçanetas de hospitais e destacado a extrema importância de procedimentos que minimizem o contágio, como higienizaçao das maos e das superfícies frequentemente manuseadas.44,45 Algumas bactérias, como a Escherichia coli, classificadas como Gram-negativas, dificilmente sao eliminadas por ativos antimicrobianos. Isso pode ser explicado pela presença de uma membrana externa adicional complexa incluindo duas bicamadas lipídicas.43 Na presença de qualquer ameaça, a membrana externa atua como barreira de proteçao física e funcional, inibindo a penetraçao de antibióticos e acionando mecanismos de defesa. Essas bactérias também sao encontradas como contaminantes em maçanetas46 e trabalhos presentes na literatura tem reportado efeitos promissores da TFDA na inibiçao desta classe de microrganismos.47,48 Já bactérias como a Staphylococcus aureus sao mais facilmente atingidas pela atividade fotodinâmica, visto que nao possuem membrana de proteçao externa e sua camada de peptideoglicano fica exposta ao ataque de espécies citotóxicas.30,37,47 Além de bactérias, o controle positivo demonstrou um grande crescimento de espécies de fungos filamentosos. Os fungos também denotam grande preocupaçao da área médica. Estes microrganismos apresentam elevada resistência devido à presença de uma membrana nuclear que representa uma barreira adicional à penetraçao de medicamentos. No entanto, vários estudos tem demonstrado a atividade fotodinâmica do fenotiazínico Azul de Metileno capaz de causar danos estruturais na membrana fúngica.48-50 Como descrito anteriormente, é conhecido que mesmo mantido no escuro o Azul de metileno possui atividade antimicrobiana. Essa característica do corante fenotiazínico é utilizada, por exemplo, em meios de cultura seletivos à bactérias gram-negativas, como o ágar eosina-azul de metileno. Isso ocorre pois o AM é capaz de inibir o crescimento de bactérias gram-positivas.43 Os testes realizados com este corante, no entanto, indicaram que a atividade do AM no escuro (Figura 3A) é baixa quando comparada a açao fotodinâmica ilustrada pela placa que foi iluminada por LEDs vermelhos (30 minutos de iluminaçao, Figura 3B). Nota-se que a iluminaçao acarretou em efeitos fotodinâmicos pronunciados, dado o mínimo nível de crescimento microbiano observado. Estes resultados demonstram a potencialidade fotodinâmica em danos celulares nas mais diversas espécies de microrganismos.
Figura 3. Placas de crescimento microbiano em meio de cultura contendo Azul de Metileno: (A) sem iluminaçao e (B) iluminada por trinta minutos (imagens obtidas após 10 dias da iluminaçao)
Nos experimentos realizados, a Eritrosina B mostrou-se também extremamente eficaz na inibiçao do crescimento microbiano, como ilustrado na comparaçao entre as Figuras 4A e 4B, na ausência e presença de luz, respectivamente. Comparada ao controle positivo, a amostra contendo Eritrosina B, mesmo sem iluminaçao, apresentou diminuiçao do crescimento microbiano. Contudo, a placa exposta à iluminaçao por trinta minutos com LEDs verdes nao apresentava qualquer sinal de crescimento de microrganismos, mesmo após dez dias.
 Figura 4. Placas de crescimento microbiano em meio de cultura contendo Eritrosina: (A) sem iluminaçao e (B) iluminada por 30 minutos (imagens obtidas após 10 dias da iluminaçao)
Comparando a açao fotodinâmica de ambos os corantes, nota-se que a ERI inibiu completamente o crescimento microbiológico, enquanto que para o AM um pouco de fungos filamentosos ainda podem ser observados na amostra iluminada (Figura 3B). Esse fato poderia ser explicado devido à diferença de potência dos LEDs, maior absorçao de fótons ou ainda maior rendimento quântico de oxigênio singleto por parte do sistema com a Eritrosina, uma vez que a concentraçao dos FS é similar. A discussao acima sob o ponto de vista quantitativo será dada para dirimir essas dúvidas. Foi necessário entao, entre outros, realizar o mesmo experimento avaliando se apenas a iluminaçao seria uma causa de inativaçao dos microrganismos (Figura 5).
 Figura 5. Placas de: (A) controle positivo 2 iluminada pelo sistema LEDverd com λmax= 506 nm e (B) controle positivo 3 iluminada pelo sistema LEDverm com λmax= 632 nm
A análise da Figura 5 mostra que na ausência do corante, a iluminaçao nao é capaz de impedir o crescimento de bactérias e fungos sobre o meio de cultura. Isso confirma que a inibiçao vista nos casos anteriores ocorre necessariamente devido a processos fotodinâmicos dos corantes. Esses experimentos sao somente de controles. Vários fatores podem estar atuando independentemente ou sinergicamente na atividade fotodinâmica dos FS utilizados, podendo justificar as diferenças observadas. Primeiramente, apesar da concentraçao empregada para ambos FS ser muito semelhante, é preciso salientar que a absortividade molar da ERI é significativamente superior à do AM, o que afeta o número de fótons absorvidos. Outro fator atrelado à absorçao de luz que pode estar corroborando com o maior efeito fotodinâmico apresentado pela ERI é a sua elevada eficiência na geraçao de 1O2, relativamente superior à do AM, (AM: ΦΔ1O2 = 0,5025 e ERI: ΦΔ1O2 = 0,6351). Esse é sem dúvida um importante parâmetro relativo à morte dos microrganismos. Contudo, a geraçao de 1O2 depende da quantidade de luz que o FS está recebendo por unidade de tempo, isto é, a dose de luz/irradiância por tempo. No entanto, a determinaçao dos valores de irradiância para cada fonte de luz utilizada (Tabela 2) demonstrou que o sistema de LEDs vermelhos apresenta irradiância superior à do sistema verde, o que vai contra os resultados observados. Isto demonstra que para a eficiência fotodinâmica existem vários fatores a serem considerados.
Dentro desses fatores, um dos mais determinantes é o nível de sobreposiçao espectral (área) entre cada FS e sua respectiva fonte de excitaçao. As sobreposiçoes sao apresentadas na Figura 6. Nota-se, na Figura 6, que tanto no sistema AM/LEDverm como no sistema ERI/LEDverd houve significativa sobreposiçao espectral. No entanto, uma análise visual qualitativa indica que apesar da maior irradiância da fonte de luz vermelha, a sobreposiçao foi relativamente superior para o sistema ERI/LEDverd. Dessa forma, aliado a uma maior absortividade da ERI (2,5 vezes maior), uma maior quantidade de fótons sao absorvidos por parte do corante xantênico em detrimento do fenotiazínico. Com intuito de analisar os dados de maneira quantitativa, foi entao calculada a potência total absorvida em cada sistema, conforme representado na Figura 7. Os dados foram obtidos seguindo-se o descrito por Rabello e colaboradores.38
 Figura 6. Sobreposiçao dos espectros de emissao relativa dos LEDs e da absorçao eletrônica dos corantes em água: (A) AM/LEDverm e (B) ERI/LEDverd, soluçao tamponada (pH 7,4)
 Figura 7. Representaçao espectral da potência de luz total (PEm) emitida pelos diodos emissores de luz (LEDs) e potência absorvida pelos FS (PAbs): (A) AM e (B) ERI
A análise da Figura 7 mostra que a PAbs pelo sistema AM/LEDverm é bastante inferior à PAbs pelo sistema ERI/LEDverd. A partir dos valores de PAbs foi possível estimar a porcentagem de luz absorvida por cada FS e o respectivo número de fótons realmente absorvidos (NAbs). Os dados obtidos encontram-se na Tabela 2. Diante dos resultados apresentados na Tabela 2, apesar da maior irradiância do LEDverm em relaçao ao LEDverd, pode-se inferir que de fato a ERI teve a dose de luz absorvida significativamente superior à do AM (praticamente 5x). Dessa forma, o maior efeito fotodinâmico da ERI pode ser plenamente justificado pela associaçao entre a maior dose de luz absorvida atrelada à maior sobreposiçao espectral e elevados valores de absortividade molar, bem como a maior geraçao de 1O2 previamente reportados na literatura.33,34 Ainda assim, os efeitos observados para o AM foram bastante satisfatórios, sendo ambos FS fortes candidatos a aplicaçoes biomédicas no controle de microrganismos. Obviamente no aspecto bioquímico se deve ainda considerar a importante interaçao entre os corantes (catiônico AM e o dianiônico ERI) com os microrganismos investigados, o que no trabalho em questao nao foi o foco. Acrescenta-se que no intuito de formar amplos conceitos aos acadêmicos, a totalidade da prática proposta é condizente. No entanto, devido às dificuldades de terem-se os equipamentos e materiais adequados aliados a questoes de tempo de aulas experimentais, é factível uma reduçao nos experimentos. Por exemplo, a ausência de um medidor de potência/irradiância para os LEDs e/ou ausência de um espectrofluorímetro para a determinaçao do espectro de emissao dos LEDs impedem a análise quantitativa dos resultados. Entretanto torna-se importante ter em mente as propriedades físicas da luz e seus processos de absorçao o que permite executar qualitativamente o experimento, bem como efetuar-se a escolha adequada do par FS/LED. No caso do AM, a cor azul implica em nao absorçao da luz azul, cor enxergada, e portanto absorçao de luz na regiao complementar conforme exemplificado pelo disco de Newton (Figura 8), ou seja, absorçao de luz na regiao do laranja/vermelho (no caso usou-se LEDverm). No caso da ERI, sua coloraçao rosa implica em absorçao de luz na regiao próxima a amarelo/verde (LEDverd) conforme novamente justificado pela Figura 8.
 Figura 8. Disco de Newton indicando as cores complementares
Outra simplificaçao possível é o uso de apenas um corante fotossensibilizador. Neste caso, somente seria demonstrada a atividade fotodinâmica FS/LED, sem a necessidade de cálculos de fótons efetivamente absorvidos. Alternativamente, pode-se variar a concentraçao do corante ou a distância de iluminaçao. Ainda é possível avaliar a atividade de outros compostos, como por exemplo da clorofila (ΦΔ1O2 = 0,44),52 cuja cor verde implica em absorçao de luz vermelha (Figura 8) e é facilmente extraída de folhas de espinafre. Com relaçao à fonte de luz, várias alternativas sao possíveis, por exemplo, lanterna de celular ou mesmo a luz solar com os cuidados necessários para que o meio de cultura nao seja liquefeito ou contaminado nao intencionalmente e inviabilize o experimento. Por outro lado, para cursos de farmácia, bioquímica e biologia também sao possíveis modificaçoes tomando-se bactérias e fungos previamente selecionados, permitindo uma abordagem bastante ampla seguida de discussoes sobre a estruturaçao de suas membranas que atuam como barreiras de proteçao.
CONCLUSOES No experimento descrito neste trabalho evidencia-se claramente a atividade fotodinâmica de dois corantes comerciais de fácil aquisiçao. A Eritrosina B apresentou uma inibiçao maior que o Azul de Metileno. Essa maior eficiência mostrou-se associada ao rendimento quântico de oxigênio singleto e a um maior número de fótons efetivamente absorvidos por esse corante, uma vez que a sobreposiçao espectral da ERI/LEDverd foi maior do que a do par AM/LEDverm. Desse modo, discussoes acerca de reaçoes fotoquímicas em cursos de química ou mesmo sobre controle microbiológico em aulas de biologia podem se tornar mais interessantes e contextualizadas. O professor pode se utilizar deste experimento para introduzir discussoes sobre o uso inadequado de antibióticos, técnicas de tratamento de câncer ou de doenças microbianas, conceitos teóricos de espectroscopia e fotoquímica, entre outros tantos assuntos englobados através desta atividade experimental. Por fim, este experimento, com as devidas simplificaçoes e adaptaçoes, pode ser incluído nas disciplinas práticas dos cursos de graduaçao em Química, ou ainda para aulas interdisciplinares de Farmácia, Bioquímica e Biologia.
MATERIAL SUPLEMENTAR No material suplementar, disponível em http://quimicanova.sbq.org.br em arquivo PDF de livre acesso, encontra-se detalhado o preparo do sistema LED utilizado (Figura 1S), assim como a iluminaçao das placas (Figura 2S). Acrescentam-se os procedimentos detalhados da medida da irradiância dos LEDs e cálculo do número de fótons absorvidos realmente pelos corantes (NAbs).
AGRADECIMENTOS Os autores agradecem à UGF/SETI-PR, à Fundaçao Araucária/SETI-PR, ao CNPq e à CAPES pelo suporte financeiro.
1. Abdel-Kader, M. H. In Photodynamic Therapy - from theory to application; Abdel-Kader, M. H., ed.; Springer: Berlin, 2014; pp. 3-22. 2. Figueiras, C. A. L.; Quim. Nova Esc. 1996, 22. 3. Machado, A. E. da H.; Quim. Nova 2000, 23, 237. 4. Simplicio, F. I.; Maionchi, F.; Hioka, N.; Quim. Nova 2002, 25, 801. 5. MacDonald, I. J.; Dougherty, T. J.; J. Porphyrins Phthalocyanines 2001, 5, 105. 6. Celli, J. P.; Spring, B. Q.; Rizvi, I.; Evans, C. L.; Samkoe, K. S.; Verma, S.; Pogue, B. W.; Hasan, T.; Chem. Rev. 2010, 110, 2795. 7. Dougherty, T. J.; Gomer, C. J.; Henderson, B. W.; Jori, G.; Kessel, D.; Korbelik, M.; Moan, J.; Peng, Q.; J. Natl. Cancer Inst. 1998, 90, 889. 8. Jori, G.; Fabris, C.; Soncin, M.; Ferro, S.; Coppellotti, O.; Dei, D.; Fantetti, L.; Chiti, G.; Roncucci, G.; Lasers Surg. Med. 2006, 38, 468. 9. Wainwright, M.; Color. Technol. 2017, 133, 3. 10. Wainwright, M.; Maisch, T.; Nonell, S.; Plaetzer, K.; Almeida, A.; Tegos, G. P.; Hamblin, M. R.; Lancet Infect. Dis. 2017, 17, 49. 11. Wainwright, M.; Int. J. Antimicrob. Agents 2014, 44, 26. 12. Perussi, J. R.; Quim. Nova 2007, 30, 988. 13. Wainwright, M.; Mohr, H.; Walker, W. H.; J. Photochem. Photobiol., B 2007, 86, 45. 14. Bagnato, V. S.; Kurachi, C.; Ferreira, J.; Marcassa, L. G.; Sibata, C. H.; Allison, R. R.; Photodiagn. Photodyn. Ther. 2005, 2, 107. 15. Eduardo, C. de P.; Bello-Silva, M. S.; Ramalho, K. M.; Lee, E. M. R.; Aranha, A. C. C.; Rev. Assoc. Paul. Cir. Dent. 2015, 69, 226. 16. Nagata, J. Y.; Hioka, N.; Kimura, E.; Batistela, V. R.; Terada, R. S. S.; Graciano, A. X.; Baesso, M. L.; Hayacibara, M. F.; Photodiagn. Photodyn. Ther. 2012, 9, 122. 17. Marotti, J.; Tortamano, P.; Cai, S.; Ribeiro, M. S.; Franco, J. E. M.; de Campos, T. T.; Lasers Med. Sci. 2013, 28, 303. 18. Issa, M. C. A.; Manela-Azulay, M.; An. Bras. Dermatol. 2010, 85, 501. 19. de Melo, W. C.; Avci, P.; de Oliveira, M. N.; Gupta, A.; Vecchio, D.; Sadasivam, M.; Rakkiyappan, C.; Huang, Y.-Y.; Yin, R.; Perussi, L. R.; Tegos, G. P.; Perussi, J. R.; Dai, T.; Hamblin, M. R.; Expert Rev. Anti. Infect. Ther. 2013, 11, 669. 20. Rosa, L. P.; Silva, F. C.; Vieira, R. L.; Tanajura, B. R.; Gusmao, A. G. da S.; de Oliveira, J. M.; dos Santos, N. A. C.; Bagnato, V. S.; Photodiagn. Photodyn. Ther. 2017, 19, 235. 21. Weijer, R.; Broekgaarden, M.; Kos, M.; van Vught, R.; Rauws, E. A. J.; Breukink, E.; van Gulik, T. M.; Storm, G.; Heger, M.; J. Photochem. Photobiol., C 2015, 23, 103. 22. Schirmer, R. H.; Adler, H.; Pickhardt, M.; Mandelkow, E.; Neurobiol. Aging 2011, 32, 7. 23. Oz, M.; Lorke, D. E.; Petroianu, G. A.; Biochem. Pharmacol. 2009, 78, 927. 24. Santin, L. R. R.; Santos, S. C. dos; Novo, D. L. R.; Bianchini, D.; Gerola, A. P.; Braga, G.; Caetano, W.; Moreira, L. M.; Bastos, E. L.; Romani, A. P.; de Oliveira, H. P. M.; Dyes Pigm. 2015, 119, 12. 25. Tardivo, J. P.; Giglio, A. del; Oliveira, C. S.; Gabrielli, D. S.; Junqueira, H. C.; Tada, D. B.; Severino, D.; Turchiello, R. de F.; Baptista, M. S.; Photodiagn. Photodyn. Ther. 2005, 2, 175. 26. Tardivo, J. P.; Del Giglio, A.; Paschoal, L.; Ito, A.; Baptista, M.; Photodiagn. Photodyn. Ther. 2004, 1, 345. 27. Lee, Y. S.; Wurster, R. D.; Cancer Lett. 1995, 88, 141. 28. Trindade, G. S.; Farias, S. L. A.; Rumjanek, V. M.; Capella, M. A. M.; Cancer Lett. 2000, 151, 161. 29. Wainwright, M.; Phoenix, D. a; Gaskell, M.; Marshall, B.; J. Antimicrob. Chemother. 1999, 44, 823. 30. Wainwright, M. Y.; Phoenix, D. A.; Laycock, S. L.; Wareing, D. R. A.; Wright, P. A.; FEMS Microbiol Lett. 1998, 160, 177. 31. Peloi, L. S.; Biondo, C. E. G.; Kimura, E.; Politi, M. J.; Lonardoni, M. V. C.; Aristides, S. M. A.; Dorea, R. C. C.; Hioka, N.; Silveira, T. G. V.; Exp. Parasitol. 2011, 128, 353. 32. Tardivo, J. P.; Serrano, R.; Zimmermann, L. M.; Diabet. Foot Ankle 2017, 8, 1. 33. Gandin, E.; Lion, Y.; Van de Vorst, A.; Photochem. Photobiol. 1983, 37, 271. 34. Batistela, V. R.; Pellosi, D. S.; De Souza, F. D.; Da Costa, W. F.; De Oliveira Santin, S. M.; De Souza, V. R.; Caetano, W.; De Oliveira, H. P. M.; Scarminio, I. S.; Hioka, N.; Spectrochim. Acta, Part A 2011, 79, 889. 35. Fracalossi, C.; Yuri, J.; Silva, D.; Sano, R.; Terada, S.; Hioka, N.; Luciano, M.; Sato, F.; Luiz, P.; Caetano, W.; Fujimaki, M.; Photodiagn. Photodyn. Ther. 2016, 15, 127. 36. Wood, S.; Metcalf, D.; Devine, D.; Robinson, C.; J. Antimicrob. Chemother. 2006, 57, 680. 37. Yassunaka, N. N.; de Freitas, C. F.; Rabello, B. R.; Santos, P. R.; Caetano, W.; Hioka, N.; Nakamura, T. U.; de Abreu Filho, B. A.; Mikcha, J. M. G.; Curr. Microbiol. 2015, 71, 243. 38. Rabello, B. R.; Gerola, A. P.; Pellosi, D. S.; Tessaro, A. L.; Aparício, J. L.; Caetano, W.; Hioka, N.; J. Photochem. Photobiol., A 2012, 238, 53. 39. Maluta, J. R.; Quim. Nova 2014, 37, 1244. 40. Rapp, T. L.; Phillips, S. R.; Dmochowski, I. J.; J. Chem. Educ. 2016, 93, 2101. 41. Prabpal, J.; Vilaivan, T.; Praneenararat, T.; J. Chem. Educ. 2017, 94, 1137. 42. Atkins, P.; de Paula, J.; Físico-Química, 9a ed., LTC Editora: Sao Paulo, 2012. 43. Madigan, M. T.; Microbiologia de Brock, 14a ed.; Artmed: Sao Paulo, 2016. 44. Silva, S. A.; Deuschle, R. A. N.; Mion, C. D. C. M.; Revista Saúde (Santa Maria) 2012, 38, 129. 45. Oie, S.; Hosokawa, I.; Kamiya, A.; J. Hosp. Infect. 2002, 51, 140. 46. Bashir, S. F.; Muhammad, H.; Sani, N. M.; Kawo, A. H.; J. Pharm. Biol. Sci. 2016, 11, 53. 47. Monteiro, J. S. C.; Oliveira, S. C. P. S. De; Santos, G. M. P.; José, F.; Sampaio, P.; Guilherme, L.; Soares, P.; Pinheiro, A. L. B.; Lasers Med. Sci. 2017, 29. 48. Peloi, L. S.; Soares, R. R. S.; Biondo, C. E. G.; Souza, V. R.; Hioka, N.; Kimura, E.; J. Biosci. 2008, 33, 231. 49. Teichert, M. C.; Jones, B. A.; Usacheva, M. N.; Biel, M. A.; Oral Surg. Oral Med. Oral Pathol. 2002. 50. Baltazar, L. M.; Ray, A.; Santos, D. A.; Cisalpino, P. S.; Friedman, A. J.; Nosanchuk, J. D.; Front. Microbiol. 2015, 6, 1. 51. Pellosi, D. S.; Estevao, B. M.; Freitas, C. F.; Tsubone, T. M.; Caetano, W.; Hioka, N.; Dyes Pigm. 2013, 99, 705. 52. Gerola, A. P.; Semensato, J.; Pellosi, D. S.; Batistela, V. R.; Rabello, B. R.; Hioka, N.; Caetano, W.; J. Photochem. Photobiol., A 2012, 232, 14. |
On-line version ISSN 1678-7064 Printed version ISSN 0100-4042
Qu�mica Nova
Publica��es da Sociedade Brasileira de Qu�mica
Caixa Postal: 26037
05513-970 S�o Paulo - SP
Tel/Fax: +55.11.3032.2299/+55.11.3814.3602
Free access







